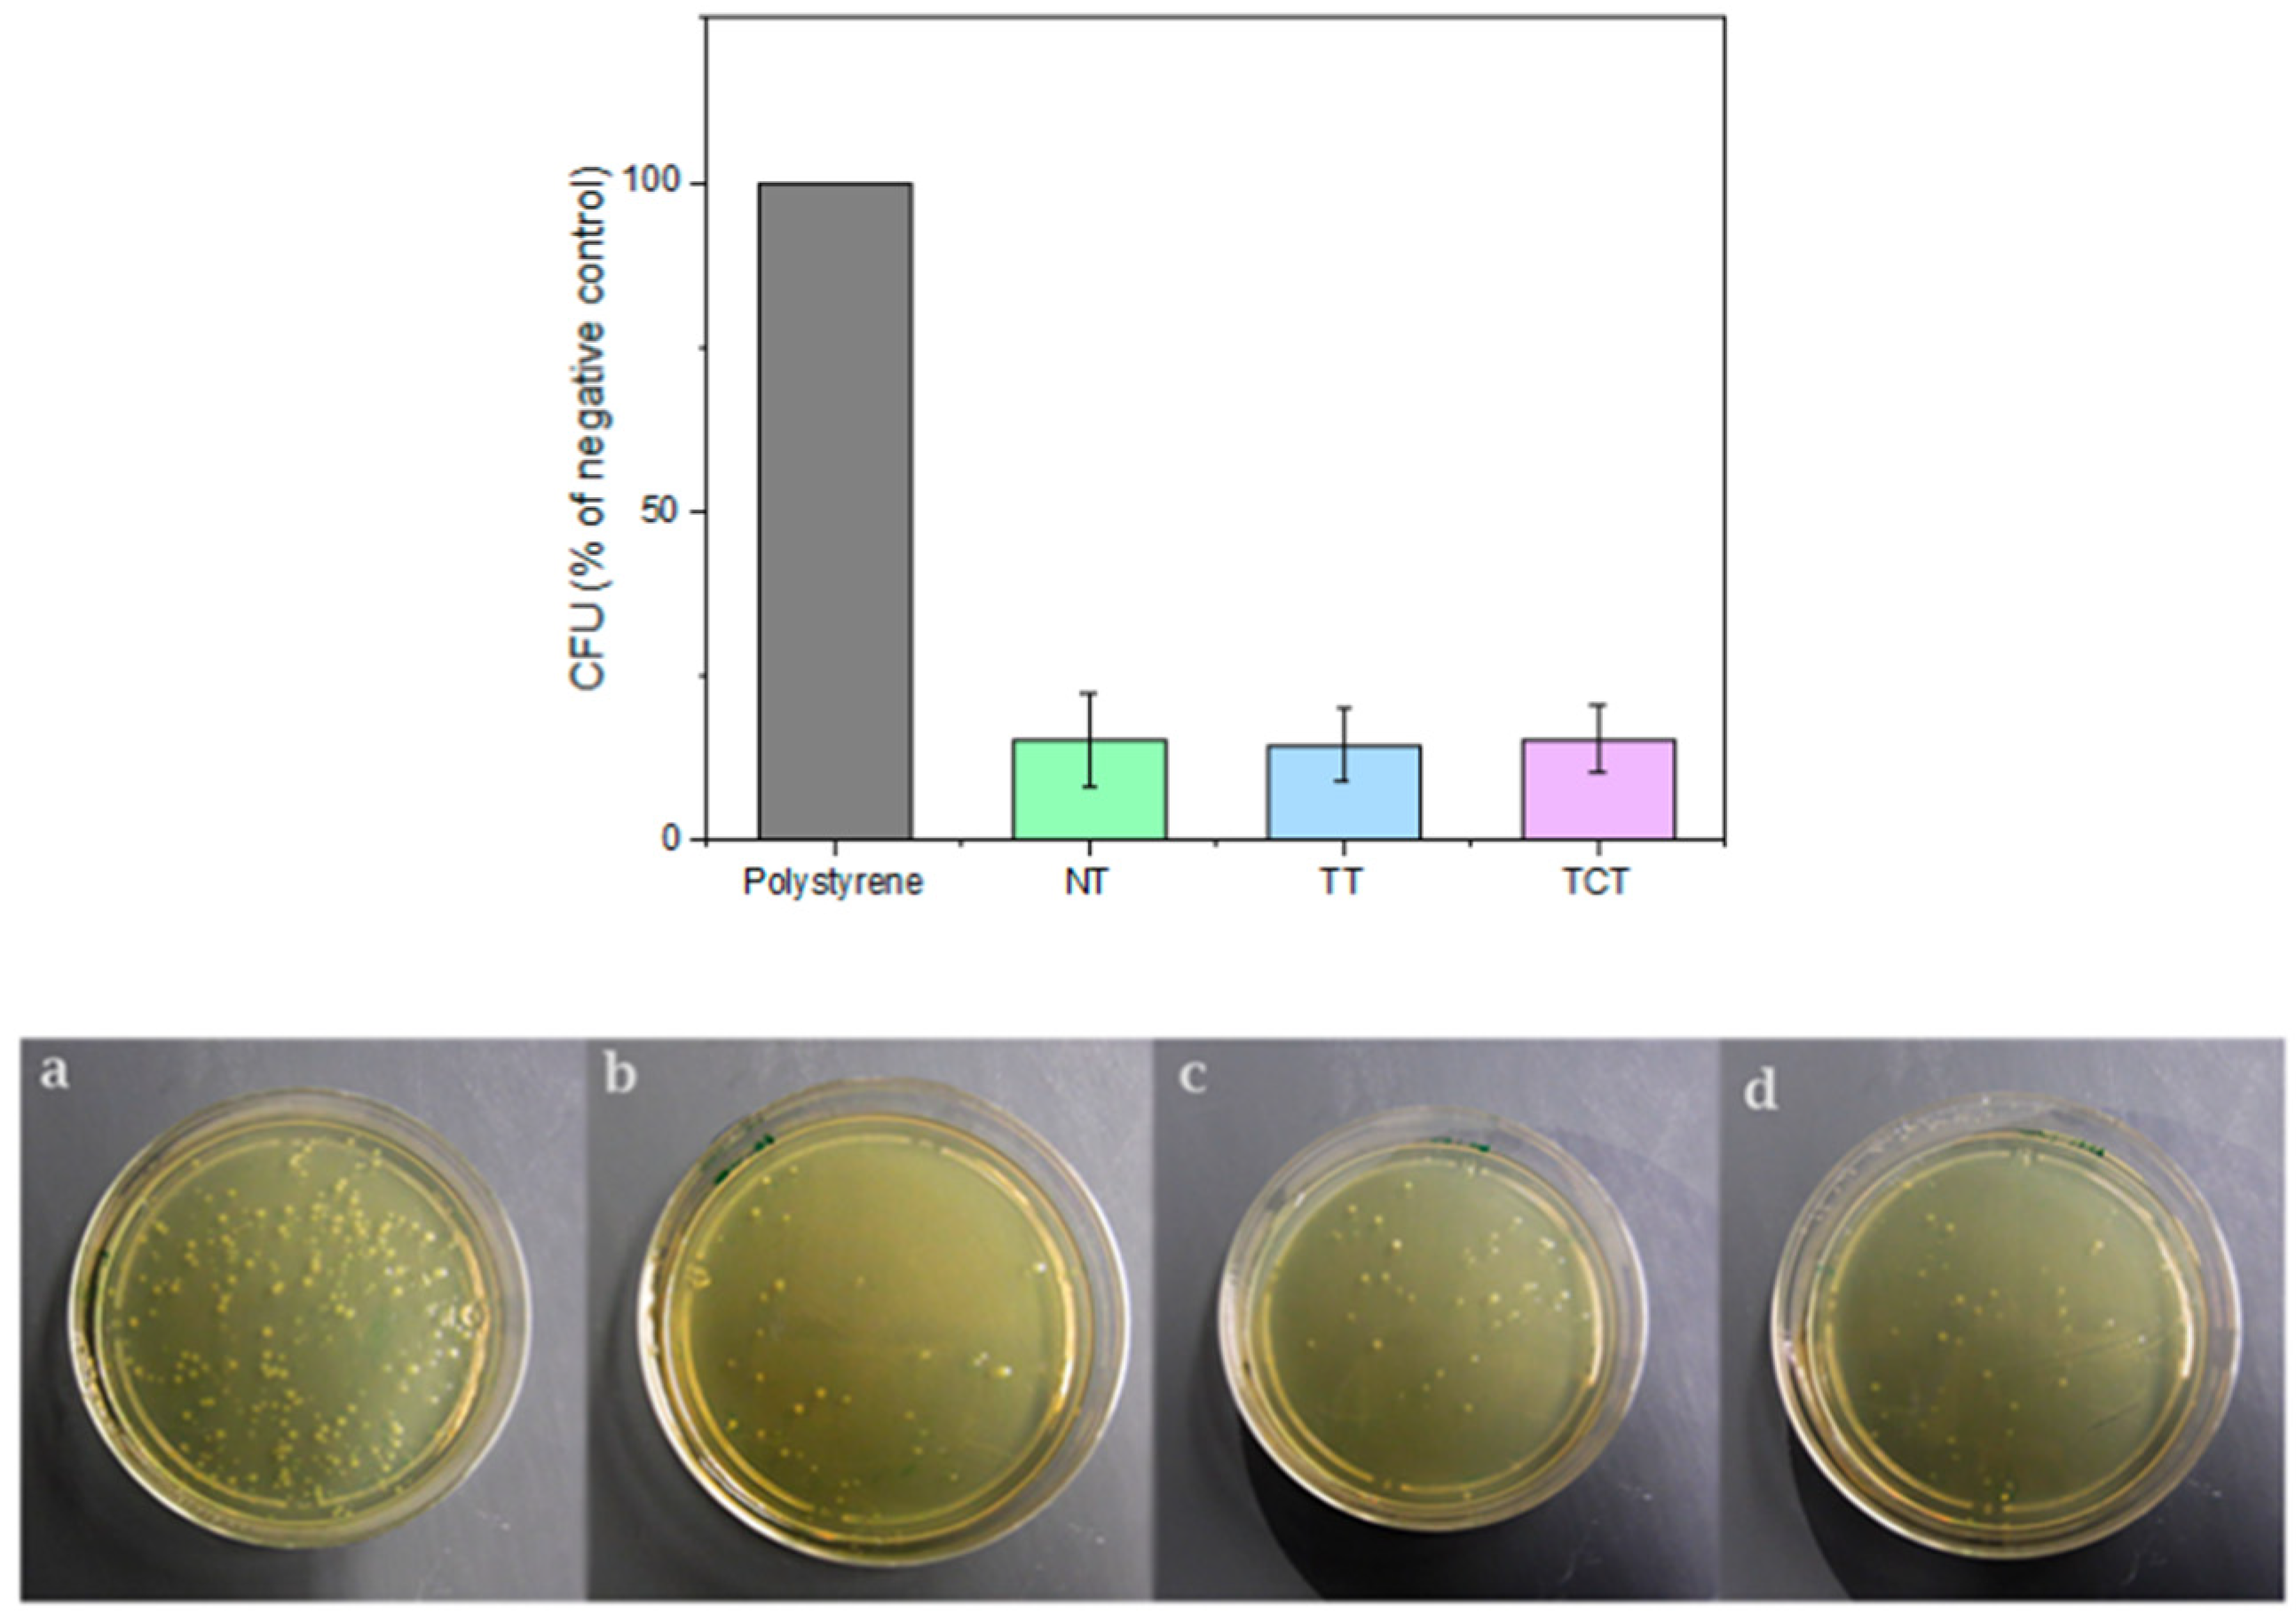

Bioactive Silicon Nitride Implant Surfaces with Maintained Antibacterial Properties
Abstract
:1. Introduction
2. Materials and Methods
2.1. Materials
2.2. Surface Modifications
2.3. Material Characterization
2.3.1. X-ray Diffraction (XRD)
2.3.2. X-ray Photoelectron Spectroscopy (XPS)
2.3.3. Scanning Electron Microscopy (SEM)
2.3.4. Computed Microtomography Scans (μCT)
2.4. Immersion Assay
2.5. Optical Profilometry
2.6. Bacterial Testing
2.6.1. Bacterial Culture
2.6.2. Bacterial Attachment Assay
2.7. Statistical Analysis
3. Results and Discussion
3.1. XRD
3.2. XPS
3.3. SEM before the Immersion Assay
3.4. Computed Microtomography Scans
3.5. ICP-OES
3.6. Apatite Formation
3.7. Optical Profilometry
3.8. Colony Forming Unit Assay
4. Conclusions
Author Contributions
Funding
Data Availability Statement
Acknowledgments
Conflicts of Interest
References
- Bal, B.S.; Rahaman, M.N. Orthopedic applications of silicon nitride ceramics. Acta Biomater. 2012, 8, 2889–2898. [Google Scholar] [CrossRef] [PubMed]
- Krstic, Z.; Krstic, V.D. Silicon nitride: The engineering material of the future. J. Mater. Sci. 2012, 47, 535–552. [Google Scholar] [CrossRef]
- Neumann, A.; Reske, T.; Held, M.; Jahnke, K.; Ragoß, C.; Maier, H.R. Comparative investigation of the biocompatibility of various silicon nitride ceramic qualities in vitro. J. Mater. Sci. Mater. Med. 2004, 15, 1135–1140. [Google Scholar] [CrossRef]
- Kue, R.; Sohrabi, A.; Nagle, D.; Frondoza, C.; Hungerford, D. Enhanced proliferation and osteocalcin production by human osteoblast-like MG63 cells on silicon nitride ceramic discs. Biomaterials 1999, 20, 1195–1201. [Google Scholar] [CrossRef] [PubMed]
- Rahaman, M.N.; Yao, A.; Bal, B.S.; Garino, J.P.; Ries, M.D. Ceramics for Prosthetic Hip and Knee Joint Replacement. J. Am. Ceram. Soc. 2007, 90, 1965–1988. [Google Scholar] [CrossRef]
- Zhou, Y.S.; Ohashi, M.; Tomita, N.; Ikeuchi, K.; Takashima, K. Study on the possibility of silicon nitride—Silicon nitride as a material for hip prostheses. Mater. Sci. Eng. C 1997, 5, 125–129. [Google Scholar] [CrossRef]
- Neumann, A.; Unkel, C.; Werry, C.; Herborn, C.U.; Maier, H.R.; Ragoß, C.; Jahnke, K. Prototype of a silicon nitride ceramic-based miniplate osteofixation system for the midface. Otolaryngol. Head Neck Surg. 2006, 134, 923–930. [Google Scholar] [CrossRef]
- Heimann, R.B. Silicon Nitride, a Close to Ideal Ceramic Material for Medical Application. Ceramics 2021, 4, 208–223. [Google Scholar] [CrossRef]
- Webster, T.J.; Patel, A.A.; Rahaman, M.N.; Sonny Bal, B. Anti-infective and osteointegration properties of silicon nitride, poly(ether ether ketone), and titanium implants. Acta Biomater. 2012, 8, 4447–4454. [Google Scholar] [CrossRef]
- Anderson, M.C.; Olsen, R. Bone ingrowth into porous silicon nitride. J. Biomed. Mater. Res. Part A 2010, 92, 1598–1605. [Google Scholar] [CrossRef]
- Howlett, C.R.; McCartney, E.; Ching, W. The effect of silicon nitride ceramic on rabbit skeletal cells and tissue. An in vitro and in vivo investigation. Clin. Orthop. Relat. Res. 1989, 244, 293–304. [Google Scholar] [CrossRef]
- Dai, Y.; Chu, L.; Luo, Z.; Tang, T.; Wu, H.; Wang, F.; Mei, S.; Wei, J.; Wang, X.; Shang, X. Effects of a Coating of Nano Silicon Nitride on Porous Polyetheretherketone on Behaviors of MC3T3-E1 Cells in Vitro and Vascularization and Osteogenesis in Vivo. ACS Biomater. Sci. Eng. 2019, 5, 6425–6435. [Google Scholar] [CrossRef] [PubMed]
- Arts, M.P.; Wolfs, J.F.C.; Corbin, T.P. Porous silicon nitride spacers versus PEEK cages for anterior cervical discectomy and fusion: Clinical and radiological results of a single-blinded randomized controlled trial. Eur. Spine J. 2017, 26, 2372–2379. [Google Scholar] [CrossRef]
- Kersten, R.F.M.R.; Öner, F.C.; Arts, M.P.; Mitroiu, M.; Roes, K.C.B.; de Gast, A.; van Gaalen, S.M. The SNAP Trial: 2-Year Results of a Double-Blind Multicenter Randomized Controlled Trial of a Silicon Nitride Versus a PEEK Cage in Patients After Lumbar Fusion Surgery. Glob. Spine J. 2021. [Google Scholar] [CrossRef] [PubMed]
- Bock, R.M.; Jones, E.N.; Ray, D.A.; Sonny Bal, B.; Pezzotti, G.; McEntire, B.J. Bacteriostatic behavior of surface modulated silicon nitride in comparison to polyetheretherketone and titanium. J. Biomed. Mater. Res. A 2017, 105, 1521–1534. [Google Scholar] [CrossRef]
- Gorth, D.J.; Puckett, S.; Ercan, B.; Webster, T.J.; Rahaman, M.; Bal, B.S. Decreased bacteria activity on Si3N4 surfaces compared with PEEK or titanium. Int. J. Nanomed. 2012, 7, 4829. [Google Scholar] [CrossRef]
- Boschetto, F.; Adachi, T.; Horiguchi, H.; Fainozzi, F.; Parmigiani, F.; Marin, E.; Zhu, W.; McEntire, B.; Yamamoto, T.; Kanamura, N.; et al. Monitoring metabolic reactions in Staphylococcus epidermidis exposed to silicon nitride using in situ time-lapse Raman spectroscopy. J. Biomed. Opt. 2018, 23, 1. [Google Scholar] [CrossRef]
- Pezzotti, G.; Bock, R.M.; McEntire, B.J.; Jones, E.; Boffelli, M.; Zhu, W.; Baggio, G.; Boschetto, F.; Puppulin, L.; Adachi, T.; et al. Silicon Nitride Bioceramics Induce Chemically Driven Lysis in Porphyromonas gingivalis. Langmuir 2016, 32, 3024–3035. [Google Scholar] [CrossRef]
- Kasliwal, M.; Tan, L.; Traynelis, V. Infection with spinal instrumentation: Review of pathogenesis, diagnosis, prevention, and management. Surg. Neurol. Int. 2013, 4, 392. [Google Scholar] [CrossRef]
- Martin, B.I.; Mirza, S.K.; Comstock, B.A.; Gray, D.T.; Kreuter, W.; Deyo, R.A. Reoperation rates following lumbar spine surgery and the influence of spinal fusion procedures. Spine 2007, 32, 382–387. [Google Scholar] [CrossRef]
- How, N.E.; Street, J.T.; Dvorak, M.F.; Fisher, C.G.; Kwon, B.K.; Paquette, S.; Smith, J.S.; Shaffrey, C.I.; Ailon, T. Pseudarthrosis in adult and pediatric spinal deformity surgery: A systematic review of the literature and meta-analysis of incidence, characteristics, and risk factors. Neurosurg. Rev. 2019, 42, 319–336. [Google Scholar] [CrossRef] [PubMed]
- Katsuura, Y.; Wright-Chisem, J.; Wright-Chisem, A.; Virk, S.; McAnany, S. The Importance of Surface Technology in Spinal Fusion. HSS J. 2020, 16, 113–116. [Google Scholar] [CrossRef] [PubMed]
- Rao, P.J.; Pelletier, M.H.; Walsh, W.R.; Mobbs, R.J. Spine Interbody Implants: Material Selection and Modification, Functionalization and Bioactivation of Surfaces to Improve Osseointegration. Orthop. Surg. 2014, 6, 81–89. [Google Scholar] [CrossRef]
- Hench, L.L. Bioceramics: From Concept to Clinic. J. Am. Ceram. Soc. 1991, 74, 1487–1510. [Google Scholar] [CrossRef]
- Ferraris, S.; Yamaguchi, S.; Barbani, N.; Cazzola, M.; Cristallini, C.; Miola, M.; Verne, E.; Spriano, S. Bioactive materials: In vitro investigation of different mechanisms of hydroxyapatite precipitation. Acta Biomater. 2020, 102, 468–480. [Google Scholar] [CrossRef] [PubMed]
- Chen, X.; Nouri, A.; Li, Y.; Lin, J.; Hodgson, P.D.; Wen, C. Effect of surface roughness of Ti, Zr, and TiZr on apatite precipitation from simulated body fluid. Biotechnol. Bioeng. 2008, 101, 378–387. [Google Scholar] [CrossRef] [PubMed]
- Pacelli, S.; Manoharan, V.; Desalvo, A.; Lomis, N.; Jodha, K.S.; Prakash, S.; Paul, A. Tailoring biomaterial surface properties to modulate host-implant interactions: Implication in cardiovascular and bone therapy. J. Mater. Chem. B 2016, 4, 1586. [Google Scholar] [CrossRef]
- Bock, R.M.; McEntire, B.J.; Bal, B.S.; Rahaman, M.N.; Boffelli, M.; Pezzotti, G. Surface modulation of silicon nitride ceramics for orthopaedic applications. Acta Biomater. 2015, 26, 318–330. [Google Scholar] [CrossRef]
- Hnatko, M.; Hičák, M.; Labudová, M.; Galusková, D.; Sedláček, J.; Lenčéš, Z.; Šajgalík, P. Bioactive silicon nitride by surface thermal treatment. J. Eur. Ceram. Soc. 2020, 40, 1848–1858. [Google Scholar] [CrossRef]
- McEntire, B.J.; Lakshminarayanan, R. Processing and Characterization of Silicon Nitride Bioceramics. Bioceram. Dev. Appl. 2016, 6, 1–9. [Google Scholar] [CrossRef]
- Fu, L.; Engqvist, H.; Xia, W. Spark plasma sintering of biodegradable Si 3 N 4 bioceramic with Sr, Mg and Si as sintering additives for spinal fusion. J. Eur. Ceram. Soc. 2018, 38, 2110–2119. [Google Scholar] [CrossRef]
- Kokubo, T.; Takadama, H. How useful is SBF in predicting in vivo bone bioactivity? Biomaterials 2006, 27, 2907–2915. [Google Scholar] [CrossRef] [PubMed]
- Fu, L.; Xiong, Y.; Carlsson, G.; Palmer, M.; Örn, S.; Zhu, W.; Weng, X.; Engqvist, H.; Xia, W. Biodegradable Si3N4 bioceramic sintered with Sr, Mg and Si for spinal fusion: Surface characterization and biological evaluation. Appl. Mater. Today 2018, 12, 260–275. [Google Scholar] [CrossRef]
- Lu, A.; Gao, Y.; Jin, T.; Luo, X.; Zeng, Q.; Shang, Z. Effects of surface roughness and texture on the bacterial adhesion on the bearing surface of bio-ceramic joint implants: An in vitro study. Ceram. Int. 2020, 46, 6550–6559. [Google Scholar] [CrossRef]
- Costa de Medeiros Dantas, L.; Paulo da Silva-Neto, J.; Souza Dantas, T.; Zago Naves, L.; Domingues das Neves, F.; Soares da Mota, A. Bacterial adhesion and surface roughness for different clinical techniques for acrylic polymethyl methacrylate. Int. J. Dent. 2016, 2016, 1–6. [Google Scholar] [CrossRef]
- Ishikawa, M.; de Mesy Bentley, K.L.; McEntire, B.J.; Bal, B.S.; Schwarz, E.M.; Xie, C. Surface topography of silicon nitride affects antimicrobial and osseointegrative properties of tibial implants in a murine model. J. Biomed. Mater. Res. Part A 2017, 105, 3413–3421. [Google Scholar] [CrossRef]
- Han, W.; Li, Y.; Chen, G.; Yang, Q. Effect of sintering additive composition on microstructure and mechanical properties of silicon nitride. Mater. Sci. Eng. A 2017, 700, 19–24. [Google Scholar] [CrossRef]
- Raider, S.I.; Flitsch, R.; Aboaf, J.A.; Pliskin, W.A. Surface Oxidation of Silicon Nitride Films. J. Electrochem. Soc. 1976, 123, 560–565. [Google Scholar] [CrossRef]
- Hing, K.A.; Saeed, S.; Annaz, B.; Buckland, T.; Revell, P.A. Microporosity Affects Bioactivity of Macroporous Hydroxyapatite Bone Graft Substitutes. Key Eng. Mater. 2004, 254–256, 273–276. [Google Scholar] [CrossRef]
- Zhang, K.; Fan, Y.; Dunne, N.; Li, X. Effect of microporosity on scaffolds for bone tissue engineering. Regen. Biomater. 2018, 5, 115–124. [Google Scholar] [CrossRef]
- Chen, X.; Chen, X.; Brauer, D.S.; Wilson, R.M.; Law, R.V.; Hill, R.G.; Karpukhina, N. Sodium is not essential for high bioactivity of glasses. Int. J. Appl. Glass Sci. 2017, 8, 428–437. [Google Scholar] [CrossRef] [PubMed]
- Hayakawa, S.; Tsuru, K.; Ohtsuki, C.; Osaka, A. Mechanism of apatite formation on a sodium silicate glass in a simulated body fluid. J. Am. Ceram. Soc. 1999, 82, 2155–2160. [Google Scholar] [CrossRef]
- Bellucci, D.; Salvatori, R.; Anesi, A.; Chiarini, L.; Cannillo, V. SBF assays, direct and indirect cell culture tests to evaluate the biological performance of bioglasses and bioglass-based composites: Three paradigmatic cases. Mater. Sci. Eng. C 2019, 96, 757–764. [Google Scholar] [CrossRef]
- Bohner, M.; Lemaitre, J. Can bioactivity be tested in vitro with SBF solution? Biomaterials 2009, 30, 2175–2179. [Google Scholar] [CrossRef] [PubMed]
- Boschetto, F.; Adachi, T.; Horiguchi, S.; Marin, E.; Paccotti, N.; Asai, T.; Zhu, W.; McEntire, B.J.; Yamamoto, T.; Kanamura, N. In situ molecular vibration insights into the antibacterial behavior of silicon nitride bioceramic versus gram-negative Escherichia coli. Spectrochim. Acta Part A Mol. Biomol. Spectrosc. 2019, 223, 117299. [Google Scholar] [CrossRef] [PubMed]
- Kushan Akin, S.R.; Dolekcekic, E.; Webster, T.J. Effect of nitrogen on the antibacterial behavior of oxynitride glasses. Ceram. Int. 2021, 47, 18213–18217. [Google Scholar] [CrossRef]

| Atomic Concentration (%) | |||||
|---|---|---|---|---|---|
| Group | Si | N | O | Si/N | Si/O |
| Non-treated | 40 | 39 | 16 | 1 | 2.5 |
| Chemically treated | 40 | 44 | 7 | 0.9 | 5.7 |
| Thermally treated | 15 | 2 | 38 | 7.5 | 0.4 |
| Thermochemically treated | 35 | 38 | 12 | 0.9 | 2.9 |
| Average Porosity (%) | |
|---|---|
| Non-treated | 68.7 ± 5.1 |
| Chemically treated | 70.2 ± 3.3 |
| Thermally treated | 70.3 ± 0.8 |
| Thermochemically treated | 69.2 ± 1.5 |
Publisher’s Note: MDPI stays neutral with regard to jurisdictional claims in published maps and institutional affiliations. |
© 2022 by the authors. Licensee MDPI, Basel, Switzerland. This article is an open access article distributed under the terms and conditions of the Creative Commons Attribution (CC BY) license (https://creativecommons.org/licenses/by/4.0/).
Share and Cite
Katsaros, I.; Zhou, Y.; Welch, K.; Xia, W.; Persson, C.; Engqvist, H. Bioactive Silicon Nitride Implant Surfaces with Maintained Antibacterial Properties. J. Funct. Biomater. 2022, 13, 129. https://doi.org/10.3390/jfb13030129
Katsaros I, Zhou Y, Welch K, Xia W, Persson C, Engqvist H. Bioactive Silicon Nitride Implant Surfaces with Maintained Antibacterial Properties. Journal of Functional Biomaterials. 2022; 13(3):129. https://doi.org/10.3390/jfb13030129
Chicago/Turabian StyleKatsaros, Ioannis, Yijun Zhou, Ken Welch, Wei Xia, Cecilia Persson, and Håkan Engqvist. 2022. "Bioactive Silicon Nitride Implant Surfaces with Maintained Antibacterial Properties" Journal of Functional Biomaterials 13, no. 3: 129. https://doi.org/10.3390/jfb13030129
APA StyleKatsaros, I., Zhou, Y., Welch, K., Xia, W., Persson, C., & Engqvist, H. (2022). Bioactive Silicon Nitride Implant Surfaces with Maintained Antibacterial Properties. Journal of Functional Biomaterials, 13(3), 129. https://doi.org/10.3390/jfb13030129

